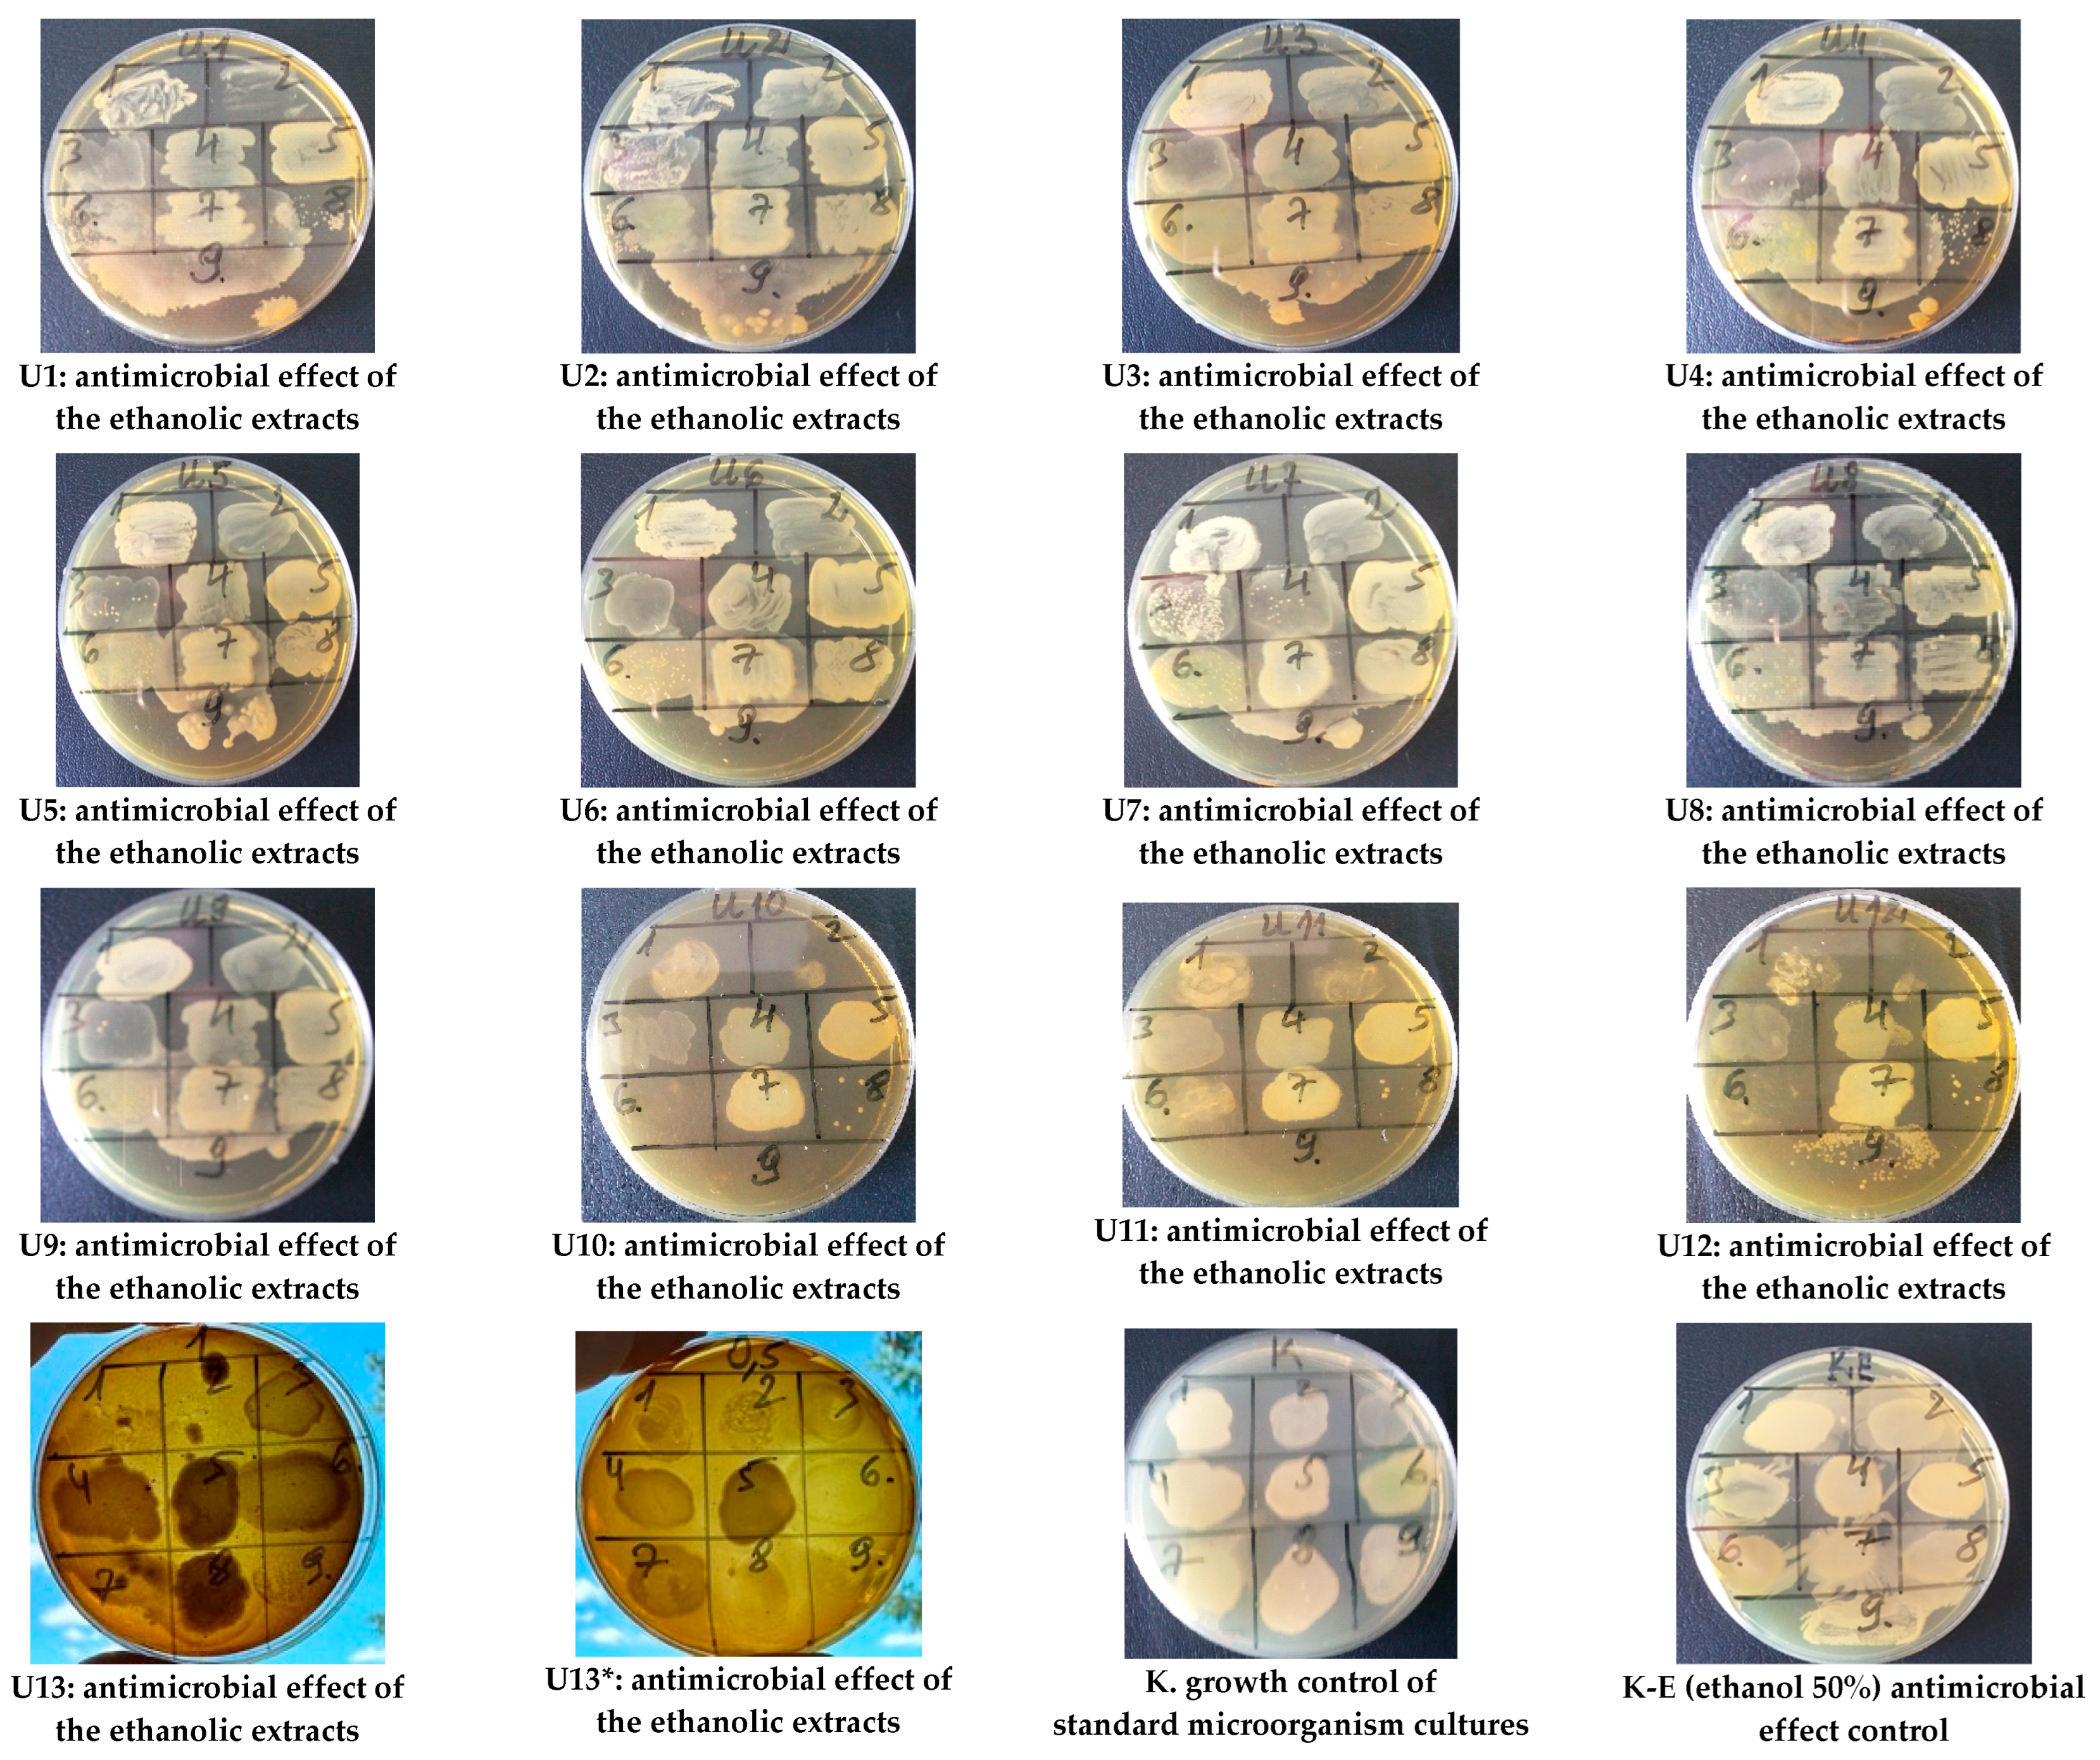
Life 14 01191 g0a1
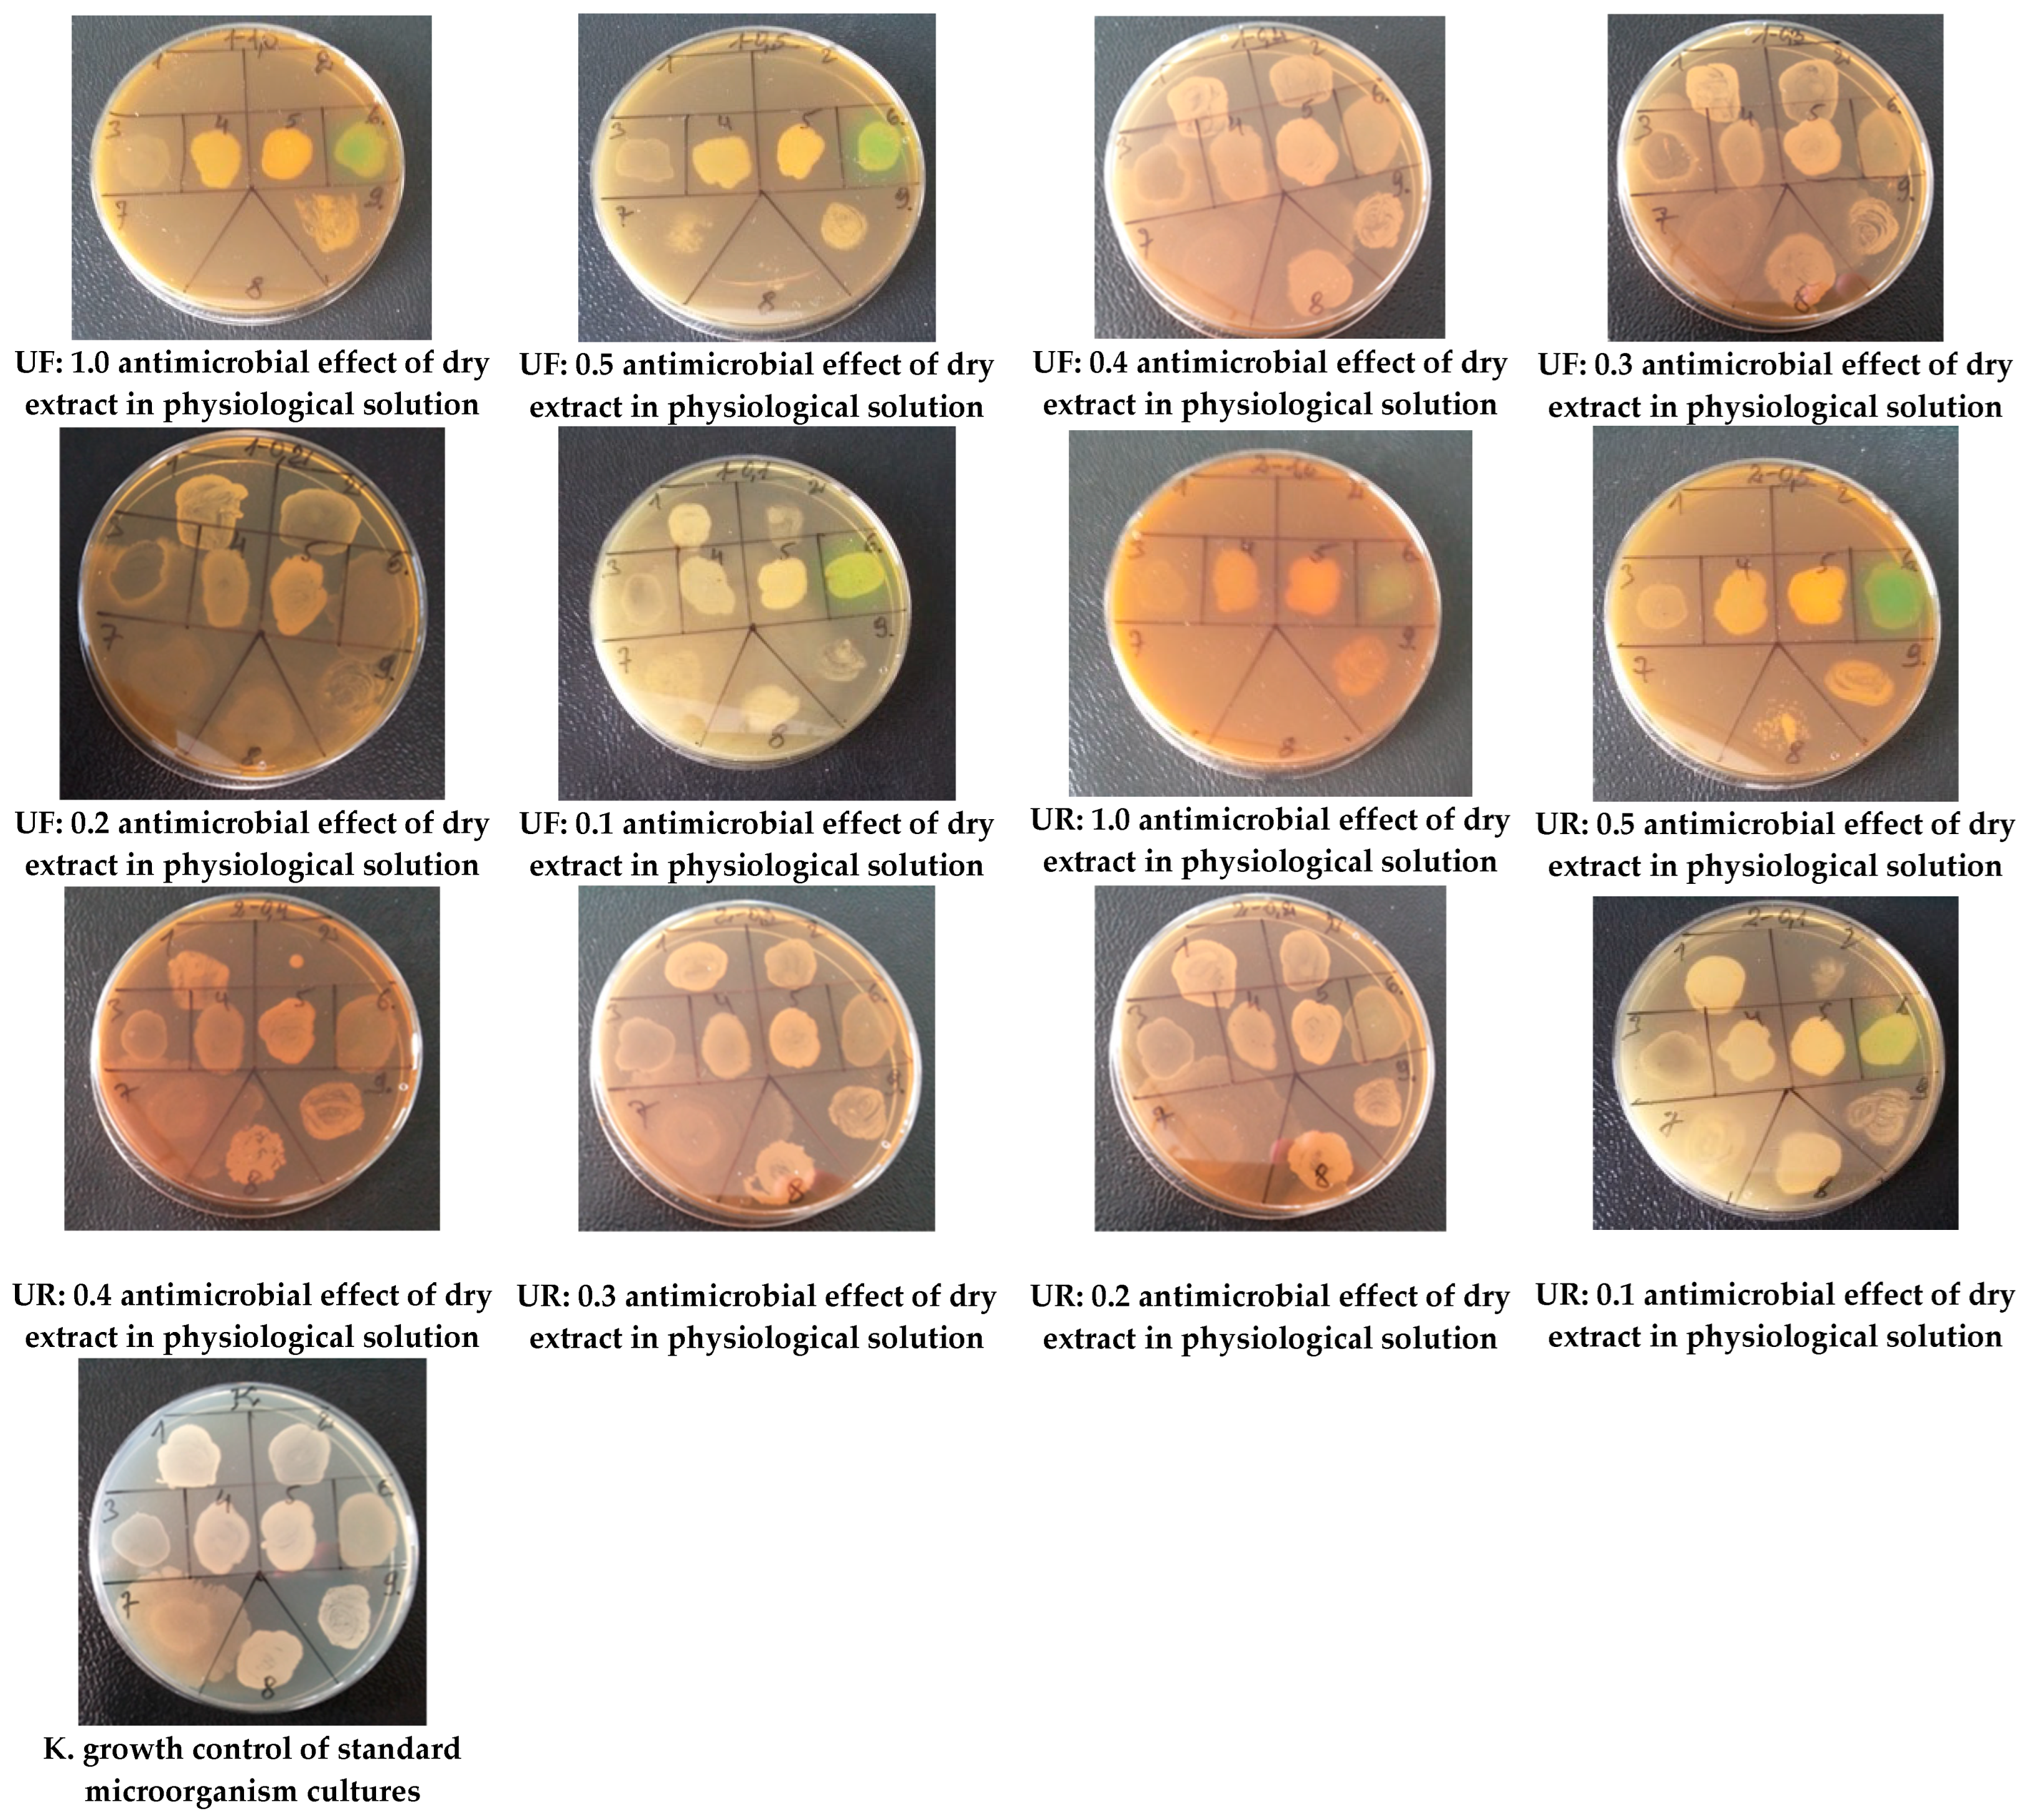
Life 14 01191 g0a2

Effect of the Phenological Stage on the Phenolic Composition, and Antioxidant and Antimicrobial Properties of Cirsium vulgare (Savi) Ten. Extracts
Abstract
1. Introduction
2. Materials and Methods
2.1. Plant Material
2.2. Chemicals
2.3. Production of Ethanolic and Dry Extracts from C. vulgare
2.4. Qualitative and Quantitative Analysis of the HPLC Method
2.5. Measurement of Antioxidant Activity by CUPRAC Assay
2.6. Determination of Antimicrobial Activity
2.7. Data Analysis
3. Results
3.1. Phenological Analysis of Phenolic Compounds
3.2. Antioxidant Activity of C. vulgare Extracts
3.3. Antimicrobial Activity of C. vulgare Extracts
4. Discussion
5. Conclusions
Author Contributions
Funding
Institutional Review Board Statement
Informed Consent Statement
Data Availability Statement
Conflicts of Interest
Appendix A
| Extract Number | Plant Part | Phenological Stage | Collection Date | Extract Type |
|---|---|---|---|---|
| U1 | Roots | end of the phenological dormancy | 11 April 2022 | Ethanolic 50% (v/v) |
| U2 | Roots | end of the phenological dormancy | 25 April 2022 | Ethanolic 50% (v/v) |
| U3 | Roots | end of the phenological dormancy | 9 May 2022 | Ethanolic 50% (v/v) |
| U4 | Leaves | end of the phenological dormancy | 25 April 2022 | Ethanolic 50% (v/v) |
| U5 | Leaves | end of the phenological dormancy | 23 May 2022 | Ethanolic 50% (v/v) |
| U6 | Leaves | mass regrowth period | 6 June 2022 | Ethanolic 50% (v/v) |
| U7 | Inflorescences | mass flowering | 30 July 2021 | Ethanolic 50% (v/v) |
| U8 | Leaves | seeds maturity | 12 September 2021 | Ethanolic 50% (v/v) |
| U9 | Inflorescences | seeds maturity | 12 September 2021 | Ethanolic 50% (v/v) |
| U10 | Leaves | end of the phenological dormancy | 25 April 2022 | Ethanolic 50% (v/v) |
| U11 | Leaves | end of the phenological dormancy | 23 May 2022 | Ethanolic 50% (v/v) |
| U12 | Leaves | mass regrowth period | 6 June 2022 | Ethanolic 50% (v/v) |
| U13 | Leaves | end of the phenological dormancy | 25 April 2022 | Ethanolic 50% (v/v) |
| U13* | Leaves | end of the phenological dormancy | 25 April 2022 | Ethanolic 50% (v/v) |
| UF | Inflorescences | seeds maturity | 12 September 2021 | Dry |
| UR | Roots | end of the phenological dormancy | 11 April 2022 | Dry |
| Active Compounds | Limit of Detection | Limit of Quantification | Range | R2 | Repeatability | Accuracy | Formula |
|---|---|---|---|---|---|---|---|
| Chlorogenic acid | 0.03 μg/mL | 0.11 μg/mL | 14.5–0.113 μg/mL | 0.9999 | 0.21% | 0.32% | 3.14e + 004X + 5.89e + 001 |
| Apigenin-7-O-glucoside | 0.320 μg/mL | 0.078 μg/mL | 20.0–0.625 μg/mL | 0.9999 | 0.41% | 0.63% | 3.53e + 004X − 1.41e + 002 |
| Apigenin | 0.063 μg/mL | 0.200 μg/mL | 16.10–0.250 μg/mL | 0.9999 | 0.12% | 0.20% | 3.42e + 004X − 1.59e + 003 |
| Luteolin | 0.053 μg/mL | 0.195 μg/mL | 110–0.214 μg/mL | 0.9999 | 0.1% | 0.15% | 4.23e + 004X + 3.89e + 002 |
| Hyperoside | 0.132 μg/mL | 0.264 μg/mL | 16.9–0.528 μg/mL | 0.9997 | 0.47% | 1.02% | 2.13e + 004X + 5.81e + 002 |
| Neochlorogen | 0.035 μg/mL | 0.105 μg/mL | 36–0.141 μg/mL | 0.9999 | 0.15% | 0.42% | 1.33e + 004X − 4.08e + 002 |
| Isoquercitrin | 0.109 μg/mL | 0.217 μg/mL | 27.85–0.870 μg/mL | 0.9999 | 0.45% | 0.86% | 2.14e + 004X + 2.09e + 003 |
| p-coumaric acid | 0.123 μg/mL | 0.404 μg/mL | 103.50–0.81 μg/mL | 0.9999 | 0.32% | 0.63% | 7.59e + 004X + 9.76e + 003 |
| Caffeic acid | 0.318 μg/mL | 1.020 μg/mL | 2.554–81.750 μg/mL | 0.99993 | 0.3% | 0.4% | 5.83 + 004X + 3.36e + 004 |
| trans-ferulic acid | 0.345 μg/mL | 1.104 μg/mL | 5.521–176.700 μg/mL | 0.99980 | 0.2% | 0.3% | 5.18e + 004X − 2.08e + 004 |
| 4-O-Caffeoilquinic acid | 0.135 μg/mL | 0.779 μg/mL | 0.859–25.500 μg/mL | 0.999 | 0.1% | 0.3% | 5.88e + 004X + 9.89e + 003 |

| Compound Name | Reference Cultures of Microorganisms | ||
|---|---|---|---|
| Staphylococcus aureus ATCC 25923 | Staphylococcus epidermidis ATCC 12228 | Pseudomonas aeruginosa ATCC 27853 | |
| U10* | NA | 16.7 mg/mL | 16.7 mg/mL |
| U12* | NA | 8.35 mg/mL | NA |
| U13* | 8.35 mg/mL | 8.35 mg/mL | NA |
| UF1.0 | 5.57 mg/mL | 5.57 mg/mL | NA |
| UF0.5 | 3 mg/mL | 5.57 mg/mL | NA |
| UR1.0 | 5.57 mg/mL | 5.57 mg/mL | NA |
| UR0.5 | 3 mg/mL | 3 mg/mL | NA |
| UR0.4 | NA | 2.47 mg/mL | NA |
| Ampicillin | ≥0.5 μg/mL | ≥0.5 μg/mL | NA |
| Gentamycin | ≥2 μg/mL | ≥2 μg/mL | ≥16 μg/mL |
| Tetracycline | ≥4 μg/mL | ≥4 μg/mL | ≥16 μg/mL |
| Ciprofloxacin | ≥2 μg/mL | ≥2 μg/mL | ≥4 μg/mL |
References
- Aggarwal, G.; Kaur, G.; Bhardwaj, G.; Mutreja, V.; Sohal, H.S.; Nayik, G.A.; Bhardwaj, A.; Sharma, A. Traditional Uses, Phytochemical Composition, Pharmacological Properties, and the Biodiscovery Potential of the Genus Cirsium. Chemistry 2022, 4, 1161–1192. [Google Scholar] [CrossRef]
- Shahrajabian, M.H. Spear Thistle (Cirsium vulgare L.) and Ramsons (Allium Ursinum L.), Impressive Health Benefits and High-Nutrient Medicinal Plants. Pharmacogn. Commun. 2021, 11, 168–171. [Google Scholar] [CrossRef]
- Forcella, F.; Randall, J.M. Biology of bull thistle, Cirsium vulgare (Savi) Tenore. Rev. Weed Sci. 1994, 6, 29–50. [Google Scholar]
- Doucet, C.; Cavers, P.B. Induced dormancy and colour polymorphism in seeds of the bull thistle Cirsium vulgare (Savi) Ten. Seed Sci. Res. 1997, 7, 399–407. [Google Scholar] [CrossRef]
- Román, J.F.C.; Hernández-Lambraño, R.E.; Rodríguez de la Cruz, D.; Agudo, J.A.S. Analysis of the Adaptative Strategy of Cirsium vulgare (Savi) Ten. in the Colonization of New Territories. Sustainability 2021, 13, 2384. [Google Scholar] [CrossRef]
- Fernández-Martínez, E.; Jiménez-Santana, M.; Centeno-Álvarez, M.; Torres-Valencia, J.M.; Shibayama, M.; Cariño-Cortés, R. Hepatoprotective effects of nonpolar extracts from inflorescences of thistles Cirsium vulgare and Cirsium ehrenbergii on Acute liver damage in rat. Pharmacogn. Mag. 2017, 13, S860–S867. [Google Scholar]
- Sabudak, T.; Orak, H.H.; Gulen, D.; Ozer, M.; Caliskan, H.; Bahrisefit, I.; Cabi, E. Investigation of some antibacterial and antioxidant properties of wild Cirsium vulgare from Turkey. Indian J. Pharm. Educ. Res. 2017, 51, S363–S367. [Google Scholar] [CrossRef]
- Nazaruk, J. Antioxidant activity and total phenolic content in Cirsium five species from the north-east region of Poland. Fitoterapia 2008, 79, 194–196. [Google Scholar] [CrossRef]
- Kozyra, M.; Głowniak, K. Phenolic acids in extracts obtained from the flowering herbs of Cirsium vulgare (Savi) Ten. growing in Poland. Acta Soc. Bot. Pol. 2013, 82, 325–329. [Google Scholar] [CrossRef]
- Jordon-Thaden, I.E.; Louda, S.M. Chemistry of Cirsium and Carduus: A role in ecological risk assessment for biological control of weeds? Biochem. Syst. Ecol. 2003, 31, 1353–1396. [Google Scholar] [CrossRef]
- Aydın Kurç, M.; Orak, H.H.; Gülen, D.; Caliskan, H.; Argon, M.; Sabudak, T. Antimicrobial and Antioxidant Efficacy of the Lipophilic Extract of Cirsium vulgare. Molecules 2023, 28, 7177. [Google Scholar] [CrossRef] [PubMed]
- Nguyen, V.; Taine, E.G.; Meng, D.; Cui, T.; Tan, W. Chlorogenic Acid: A Systematic Review on the Biological Functions, Mechanistic Actions, and Therapeutic Potentials. Nutrients 2024, 16, 924. [Google Scholar] [CrossRef]
- Sezen Karaoğlan, E.; Hancı, H.; Koca, M.; Kazaz, C. Some Bioactivities of Isolated Apigenin-7-O-glucoside and Luteolin-7-O-glucoside. Appl. Sci. 2023, 13, 1503. [Google Scholar] [CrossRef]
- Liu, M.M.; Ma, R.H.; Ni, Z.J.; Thakur, K.; Cespedes-Acuña, C.L.; Jiang, L.; Wei, Z.-J. Apigenin 7-O-glucoside promotes cell apoptosis through the PTEN/PI3K/AKT pathway and inhibits cell migration in cervical cancer HeLa cells. Food Chem. Toxicol. 2020, 146, 111843. [Google Scholar] [CrossRef] [PubMed]
- Chepel, V.; Lisun, V.; Skrypnik, L. Changes in the content of some groups of phenolic compounds and biological activity of extracts of various parts of heather (Calluna vulgaris (L.) hull) at different growth stages. Plants 2020, 9, 926. [Google Scholar] [CrossRef] [PubMed]
- Wang, B.; Sun, W.; Li, Q.; Li, Y.; Luo, H.; Song, J.; Sun, C.; Qian, J.; Zhu, Y.; Hayward, A.; et al. Genome-wide identification of phenolic acid biosynthetic genes in Salvia miltiorrhiza. Planta 2015, 241, 711–725. [Google Scholar] [CrossRef]
- Griškevičienė, U.; Marksa, M.; Ževžikovienė, A.; Kazlauskienė, D.; Vainorienė, R.; Ževžikovas, A.; Ivanauskas, L. Cirsium vulgare leaves: Isolation and identification of phenolic compounds. Chemija 2021, 32, 92–99. [Google Scholar] [CrossRef]
- Apak, R.; Güçlü, K.; Özyürek, M.; Çelik, S.E. Mechanism of antioxidant capacity assays and the CUPRAC (cupric ion reducing antioxidant capacity) assay. Microchim. Acta 2008, 160, 413–419. [Google Scholar] [CrossRef]
- Kazlauskaite, J.A.; Matulyte, I.; Marksa, M.; Lelesius, R.; Pavilonis, A.; Bernatoniene, J. Application of Antiviral, Antioxidant and Antibacterial Glycyrrhiza glabra L., Trifolium pratense L. Extracts and Myristica fragrans Houtt. Essential Oil in Microcapsules. Pharmaceutics 2023, 15, 464. [Google Scholar] [CrossRef]
- Sofowora, A.; Ogunbodede, E.; Onayade, A. The role and place of medicinal plants in the strategies for disease prevention. Afr. J. Tradit. Complement. Altern. Med. 2013, 10, 210–229. [Google Scholar] [CrossRef]
- Feduraev, P.; Chupakhina, G.; Maslennikov, P.; Tacenko, N.; Skrypnik, L. Variation in phenolic compounds content and antioxidant activity of different plant organs from Rumex crispus L. and Rumex obtusifolius L. at different growth stages. Antioxidants 2019, 8, 237. [Google Scholar] [CrossRef] [PubMed]
- Baldermann, S.; Homann, T.; Neugart, S.; Chmielewski, F.M.; Tz, K.P.G.; Deke, K.G.; Huschek, G.; Morlock, G.E.; Rawel, H.M. Selected plant metabolites involved in oxidation-reduction processes during bud dormancy and ontogenetic development in sweet cherry buds (Prunus avium L.). Molecules 2018, 23, 1197. [Google Scholar] [CrossRef]
- Mendez-Lopez, A.Y.; Lagunes-Espinoza, L.C.; González-Esquinca, A.R.; Hernández-Nataren, E.; Ortiz-García, C.F. Phenological characterization of chipilín (Crotalaria longirostrata Hook. & Arn.) and relationship between the phenological stage and chemical composition of leaves. S. Afr. J. Bot. 2023, 154, 140–148. [Google Scholar]
- Kozyra, M.; Biernasiuk, A.; Malm, A.; Chowaniec, M. Chemical compositions and antibacterial activity of extracts obtained from the inflorescences of Cirsium canum (L.) all. Nat. Prod. Res. 2015, 29, 2059–2063. [Google Scholar] [CrossRef]
- Nazaruk, J.; Gudej, J. Flavonoid compounds from the flowers of Cirsium rivulare (Jacq.) all. Acta Pol. Pharm.–Drug Res. 2003, 60, 87–89. [Google Scholar]
- Lokman Hossain, M.; Monjur-Al-Hossain, A.; Kumar Sadhu, S.; Md Lokman Hossain, C. HPLC Profiling and Evaluation of In-vitro Antioxidant Activity of Cirsium arvense L. (Family: Asteraceae). J. Pharmacogn. Phytochem. 2016, 5, 272–277. [Google Scholar]
- Kozyra, M.; Skalicka-Wozniak, K. Quantitative analysis of flavonoids and phenolic acids from inflorescences and aerial parts of selected cirsium species using ase method. Acta Pol. Pharm.–Drug Res. 2014, 71, 877–881. [Google Scholar]
- Oki, T.; Masuda, M.; Furuta, S.; Nishiba, Y.; Terahara, N.; Suda, I. Involvement of anthocyanins and other phenolic compounds in radical-scavenging activity of purple-fleshed sweet potato cultivars. J. Food Sci. 2002, 67, 1752–1756. [Google Scholar] [CrossRef]
- Demirtas, I.; Tufekci, A.R.; Yaglioglu, A.S.; Elmastas, M. Studies on the Antioxidant and Antiproliferative Potentials of Cirsium arvense subsp. vestitum. J. Food Biochem. 2017, 41. Available online: https://onlinelibrary.wiley.com/doi/full/10.1111/jfbc.12299 (accessed on 11 April 2022). [CrossRef]
- Naghiloo, S.; Movafeghi, A.; Delazar, A.; Nazemiyeh, H.; Asnaashari, S.; Dadpour, M.R. Ontogenetic variation of total phenolics and antioxidant activity in roots, leaves and flowers of Astragalus compactus Lam. (Fabaceae). BioImpacts 2012, 2, 105–109. [Google Scholar]
- Zhao, Z.W.; Chang, H.C.; Ching, H.; Lien, J.C.; Huang, H.C.; Wu, C.R. Antioxidant effects and phytochemical properties of seven Taiwanese cirsium species extracts. Molecules 2021, 26, 3935. [Google Scholar] [CrossRef] [PubMed]
- Moghaddam, M.; Naser, S.; Miran, K.; Mehdizadeh, L. Total Phenolic Content and Antioxidant Activity of Fumaria vaillantii Extract at Three Phenological Stages Assayed by Various Methods. Int. J. Hortic. Sci. Technol. 2018, 5, 93–102. [Google Scholar]
- Santos, J.A.; Fraga, H.; Malheiro, A.C.; Moutinho-Pereira, J.; Dinis, L.T.; Correia, C.; Moriondo, M.; Leolini, L.; Dibari, C.; Costafreda-Aumedes, S.; et al. A review of the potential climate change impacts and adaptation options for European viticulture. Appl. Sci. 2020, 10, 3092. [Google Scholar] [CrossRef]
- Yin, J.; Heo, S.I.; Wang, M.H. Antioxidant and antidiabetic activities of extracts from Cirsium japonicum roots. Nutr. Res. 2008, 2, 247–251. [Google Scholar] [CrossRef]
- Kim, H.H.; Jeong, S.H.; Park, M.Y.; Bhosale, P.B.; Abusaliya, A.; Kim, H.W.; Seong, J.K.; Kim, D.I.; Lee, S.J.; Park, K.I.; et al. Potential Antioxidant and Anti-Inflammatory Properties of Polyphenolic Compounds from Cirsium japonicum Extract. Int. J. Mol. Sci. 2024, 25, 785. [Google Scholar] [CrossRef]
- Álvarez-Martínez, F.J.; Barrajón-Catalán, E.; Herranz-López, M.; Micol, V. Antibacterial plant compounds, extracts and essential oils: An updated review on their effects and putative mechanisms of action. Phytomedicine 2021, 90, 153626. [Google Scholar] [CrossRef]
- Katz, L.; Baltz, R.H. Natural product discovery: Past, present, and future. J. Ind. Microbiol. Biotechnol. 2016, 43, 155–176. [Google Scholar] [CrossRef]
- Abdallah, E.M.; Alhatlani, B.Y.; Menezes, R.P.; Martins, C.H.G. Back to Nature: Medicinal Plants as Promising Sources for Antibacterial Drugs in the Post-Antibiotic Era. Plants 2023, 12, 3077. [Google Scholar] [CrossRef]
- Kabir, F.; Katayama, S.; Tanji, N.; Nakamura, S. Antimicrobial effects of chlorogenic acid and related compounds. J. Korean Soc. Appl. Biol. Chem. 2014, 57, 359–365. [Google Scholar] [CrossRef]
- Nalewajko-Sieliwoniuk, E.; Malejko, J.; Mozolewska, M.; Wołyniec, E.; Nazaruk, J. Determination of polyphenolic compounds in Cirsium palustre (L.) extracts by high performance liquid chromatography with chemiluminescence detection. Talanta 2015, 133, 38–44. [Google Scholar] [CrossRef] [PubMed]
- Su, M.; Liu, F.; Luo, Z.; Wu, H.; Zhang, X.; Wang, D.; Zhu, Y.; Sun, Z.; Xu, W.; Miao, Y. The antibacterial activity and mechanism of chlorogenic acid against foodborne pathogen pseudomonas aeruginosa. Foodborne Pathog. Dis. 2019, 16, 823–830. [Google Scholar] [CrossRef]
- Tang, X.M.; Xie, M.X.; Gou, J.L.; Chen, L.; Tian, J.L.; Zhang, X.; Lu, Y.-Y.; Wang, H.-Q. Antibacterial Activity of Plants in Cirsium: A Comprehensive Review. Chin. J. Integr. Med. 2024, 30, 835–841. [Google Scholar] [CrossRef]
- Kenny, O.; Smyth, T.J.; Walsh, D.; Kelleher, C.T.; Hewage, C.M.; Brunton, N.P. Investigating the potential of under-utilised plants from the Asteraceae family as a source of natural antimicrobial and antioxidant extracts. Food Chem. 2014, 161, 79–86. [Google Scholar] [CrossRef]
- Borawska, M.H.; Czechowska, S.K.; Markiewicz, R.; Socha, K.; Nazaruk, J.; Paka, J.; Isidorov, V.A. Enhancement of antibacterial effects of extracts from Cirsium species using sodium picolinate and estimation of their toxicity. Nat. Prod. Res. 2010, 24, 554–561. [Google Scholar] [CrossRef]
- Ashmita, C.; Pretty, R.; Lalita, S.; Dheeraj, G.; Reena, A.; Pushpa, D. Cirsium arvense: A multipotent weed. Ann. Biol. 2020, 36, 442–447. [Google Scholar]






| Ethanol Extracts of C. vulgare (mL) | |||||||||||||||
|---|---|---|---|---|---|---|---|---|---|---|---|---|---|---|---|
| Reference Cultures of Microorganisms | U1 1.0 | U2 1.0 | U3 1.0 | U4 1.0 | U5 1.0 | U6 1.0 | U7 1.0 | U8 1.0 | U9 1.0 | U10 1.0 | U11 1.0 | U12 1.0 | U13 1.0 | U13* 0.5 | Ethanol 1.0 |
| Staphylococcus aureus ATCC 25923 | NA | NA | NA | NA | NA | NA | NA | NA | NA | NA | NA | NA | 8.35 | NA | NA |
| Staphylococcus epidermidis ATCC 12228 | NA | NA | NA | NA | NA | NA | NA | NA | NA | 16.7 | NA | 8.35 | 8.35 | NA | NA |
| Enterococcus faecalis ATCC 29212 | NA | NA | NA | NA | NA | NA | NA | NA | NA | NA | NA | NA | NA | NA | NA |
| Escherichia coli ATCC 25922 | NA | NA | NA | NA | NA | NA | NA | NA | NA | NA | NA | NA | NA | NA | NA |
| Klebsiella pneumoniae ATCC 13883 | NA | NA | NA | NA | NA | NA | NA | NA | NA | NA | NA | NA | NA | NA | NA |
| Pseudomonas aeruginosa ATCC 27853 | NA | NA | NA | NA | NA | NA | NA | NA | NA | 16.7 | NA | NA | NA | NA | NA |
| Bacillus cereus ATCC 11778 | NA | NA | NA | NA | NA | NA | NA | NA | NA | NA | NA | NA | NA | NA | NA |
| Proteus vulgaris ATCC 8427 | 16.7 | NA | NA | 16.7 | NA | NA | NA | NA | NA | 16.7 | 8.35 | 8.35 | NA | NA | NA |
| Candida albicans ATCC 10231 | 16.7 | NA | 16.7 | 16.7 | 16.7 | 16.7 | 16.7 | 16.7 | 16.7 | 16.7 | 8.35 | 8.35 | NA | NA | NA |
| Amount of C. vulgare Extract (mL) | ||||||||||||
|---|---|---|---|---|---|---|---|---|---|---|---|---|
| Reference Cultures of Microorganisms | UF 1.0 | UF 0.5 | UF 0.4 | UF 0.3 | UF 0.2 | UF 0.1 | UR 1.0 | UR 0.5 | UR 0.4 | UR 0.3 | UR 0.2 | UR 0.1 |
| Staphylococcus aureus ATCC 25923 | 5.57 | 3 | NA | NA | NA | NA | 5.57 | 3 | NA | NA | NA | NA |
| Staphylococcus epidermidis ATCC 12228 | 5.57 | 3 | NA | NA | NA | NA | 5.57 | 3 | 2.47 | NA | NA | NA |
| Enterococcus faecalis ATCC 29212 | NA | NA | NA | NA | NA | NA | NA | NA | NA | NA | NA | NA |
| Escherichia coli ATCC 25922 | NA | NA | NA | NA | NA | NA | NA | NA | NA | NA | NA | NA |
| Klebsiella pneumoniae ATCC 13883 | NA | NA | NA | NA | NA | NA | NA | NA | NA | NA | NA | NA |
| Pseudomonas aeruginosa ATCC 27853 | NA | NA | NA | NA | NA | NA | NA | NA | NA | NA | NA | NA |
| Bacillus cereus ATCC 11778 | 5.57 | 3 | NA | NA | NA | NA | 5.57 | NA | NA | NA | NA | NA |
| Proteus vulgaris ATCC 8427 | 5.57 | NA | NA | NA | NA | NA | 5.57 | 3 | NA | NA | NA | NA |
| Candida albicans ATCC 10231 | NA | NA | NA | NA | NA | NA | NA | NA | NA | NA | NA | NA |
Disclaimer/Publisher’s Note: The statements, opinions and data contained in all publications are solely those of the individual author(s) and contributor(s) and not of MDPI and/or the editor(s). MDPI and/or the editor(s) disclaim responsibility for any injury to people or property resulting from any ideas, methods, instructions or products referred to in the content. |
© 2024 by the authors. Licensee MDPI, Basel, Switzerland. This article is an open access article distributed under the terms and conditions of the Creative Commons Attribution (CC BY) license (https://creativecommons.org/licenses/by/4.0/).
Share and Cite
Griskeviciene, U.; Dambrauskiene, J.; Marksa, M.; Mazeliene, Z.; Vainoriene, R.; Ivanauskas, L. Effect of the Phenological Stage on the Phenolic Composition, and Antioxidant and Antimicrobial Properties of Cirsium vulgare (Savi) Ten. Extracts. Life 2024, 14, 1191. https://doi.org/10.3390/life14091191
Griskeviciene U, Dambrauskiene J, Marksa M, Mazeliene Z, Vainoriene R, Ivanauskas L. Effect of the Phenological Stage on the Phenolic Composition, and Antioxidant and Antimicrobial Properties of Cirsium vulgare (Savi) Ten. Extracts. Life. 2024; 14(9):1191. https://doi.org/10.3390/life14091191
Chicago/Turabian StyleGriskeviciene, Urte, Justina Dambrauskiene, Mindaugas Marksa, Zaneta Mazeliene, Rimanta Vainoriene, and Liudas Ivanauskas. 2024. "Effect of the Phenological Stage on the Phenolic Composition, and Antioxidant and Antimicrobial Properties of Cirsium vulgare (Savi) Ten. Extracts" Life 14, no. 9: 1191. https://doi.org/10.3390/life14091191
APA StyleGriskeviciene, U., Dambrauskiene, J., Marksa, M., Mazeliene, Z., Vainoriene, R., & Ivanauskas, L. (2024). Effect of the Phenological Stage on the Phenolic Composition, and Antioxidant and Antimicrobial Properties of Cirsium vulgare (Savi) Ten. Extracts. Life, 14(9), 1191. https://doi.org/10.3390/life14091191

